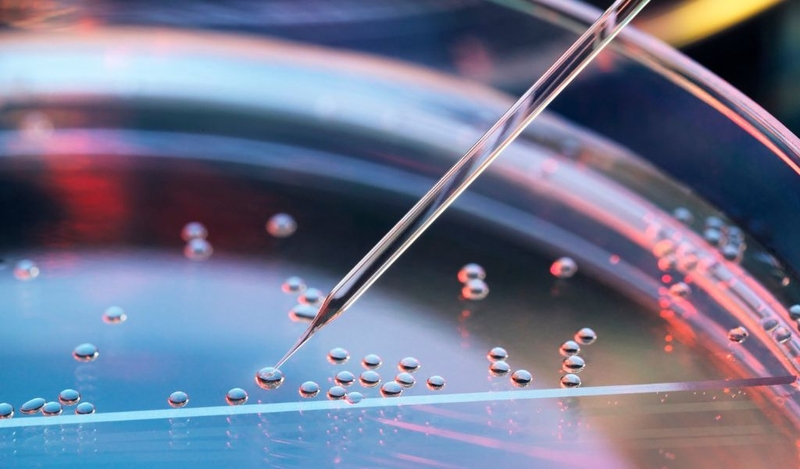
Tế bào là gì? Cấu tạo và chức năng của tế bào bình thường? 3

Tốt nghiệp Khoa Dược trường Đại học Võ Trường Toản. Có nhiều năm kinh nghiệm trong ngành Dược. Hiện đang là giảng viên cho Dược sĩ tại Nhà thuốc Long Châu.
Tế bào là gì? Cấu tạo và chức năng của tế bào bình thường?
31/12/2025
Mặc định
Lớn hơn
Tế bào là gì? Đây đơn vị cấu trúc cơ bản nhất của mọi sinh vật. Trong đó, cơ thể con người được tạo thành từ hàng nghìn tỷ tế bào. Xây dựng nên các cấu trúc của cơ thể, hấp thụ chất dinh dưỡng từ thức ăn và sau đó chuyển hóa thành năng lượng và thực hiện các chức năng chuyên biệt. Tế bào được cấu tạo từ nhiều thành phần và mỗi thành phần đều có chức năng khác nhau.
Tế bào là đơn vị cấu trúc cơ bản của mọi sinh vật, kể cả con người. Mỗi loài sinh vật có số lượng tế bào khác nhau. Có nhiều loại tế bào khác nhau, mỗi loại tế bào trong cơ thể con người thực hiện một chức năng cụ thể riêng. Tế bào tuy rất nhỏ nhưng lại thể hiện những nhiệm vụ và chức năng vô cùng quan trọng. Vậy cấu tạo và chức năng của tế bào bình thường là gì?
Tế bào là gì?
Tế bào là đơn vị cấu trúc và chức năng cơ bản nhất của mọi sinh vật, được ví như “viên gạch” tạo nên cơ thể sống. Tế bào có cấu trúc phức tạp, chứa DNA và có khả năng trao đổi chất, tự sao chép, chuyển hóa năng lượng, thực hiện các chức năng chuyên biệt để duy trì sự sống.
Đơn vị cấu trúc và chức năng cơ bản nhất của cơ thể con người là tế bào. Mỗi tế bào có một vai trò khác nhau, tham gia vào các hoạt động sinh lý bình thường. Đồng thời, giữa các tế bào bình thường, chúng thường tương tác với nhau để duy trì cân bằng nội môi hoặc sự ổn định của các chất trong cơ thể. Nhà khoa học người Đức Rudolf Virchow (1821 - 1902) đã đưa ra thuyết bệnh học tế bào. Hiện nay, với sự phát triển của y học, tất cả các bệnh tật đều liên quan đến sự rối loạn cấu trúc và chức năng của tế bào.
 Tế bào là gì? Đây là đơn vị cấu trúc và chức năng cơ bản nhất của cơ thể con người
Tế bào là gì? Đây là đơn vị cấu trúc và chức năng cơ bản nhất của cơ thể con ngườiCấu trúc và chức năng của tế bào bình thường
Để hiểu rõ hơn tế bào là gì, bạn cần hiểu cấu trúc và chức năng cơ bản của một tế bào bình thường. Tất cả các tế bào đều có điểm chung là bao gồm nhân tế bào và bào tương chứa các bào quan và một lớp màng bên ngoài.
Nhân
Nhân là nơi các hoạt động di truyền của tế bào diễn ra. Cấu tạo gồm có màng nhân, dịch nhân, nhân tế bào và chất nhiễm sắc:
- Màng nhân: Là đường phân chia giữa nhân tế bào và bào tương, liên kết với lưới nội bào. Ngoài ra còn có các ribosome bám trên bề mặt, ngoài màng nhân.
- Dịch nhân: Các thành phần của dịch nhân bao gồm nucleoprotein, glycoprotein và các enzym chuyển hóa nucleotide.
- Hạt nhân: Đây là nơi diễn ra quá trình tổng hợp RNA.
- Chất nhiễm sắc: Là cơ sở vật chất di truyền chính của tế bào, còn được gọi là DNA. Bộ nhiễm sắc thể ở người bao gồm 22 cặp nhiễm sắc thể thường và 1 cặp nhiễm sắc thể giới tính.
 Nhân là nơi các hoạt động di truyền của tế bào diễn ra gồm có màng nhân, dịch nhân, nhân tế bào và chất nhiễm sắc
Nhân là nơi các hoạt động di truyền của tế bào diễn ra gồm có màng nhân, dịch nhân, nhân tế bào và chất nhiễm sắc Bào tương
Tất cả các tế bào đều có bào tương, số lượng bào tương và bào quan thay đổi theo từng loại tế bào khác nhau và có xu hướng tăng lên khi cơ thể trưởng thành.
Tế bào gan và thận là một trường hợp đặc biệt vì có nhiều bào tương và bào quan hơn bình thường. Các bào quan chính trong tế bào tương bao gồm: ti thể, ribosome, lưới nội chất hạt và không hạt, bộ máy golgi và lysosome.
- Ti thể: Ti thể có cấu tạo là những hạt nhỏ, hình cầu hoặc bầu dục. Cấu tạo gồm 2 phần là đầu và chân. Phần đầu có nhiệm vụ sản xuất các enzyme tổng hợp năng lượng ATP. Trong khi phần chân sản xuất các enzym tham gia vào quá trình oxy hóa tế bào. Vì vậy, ti thể có nhiệm vụ sản xuất năng lượng ATP cho mọi hoạt động bình thường của cơ thể.
- Ribosome: Tất cả các tế bào bình thường đều chứa ribosome, là những hạt hình cầu nhỏ hoặc hình trứng có kích thước khác nhau. Cấu trúc bao gồm hai phần không bằng nhau là tiểu đơn vị lớn và tiểu đơn vị nhỏ. Vị trí liên kết giữa hai phần này chứa RNA vận chuyển và RNA thông tin. Nhiệm vụ chính của ribosome là tổng hợp protein và các enzym chuyển hóa của hoạt động sống tế bào.
- Lưới nội bào: Lưới nội bào là thành phần có ở tất cả các tế bào bình thường, ngoại trừ hồng cầu trưởng thành. Đây là hệ thống các túi nằm giữa khoang nhân tế bào với màng tế bào và môi trường bên ngoài. Lưới nội bào gồm 2 loại là hạt và không hạt.
- Bộ máy golgi: Bộ máy golgi chưa được nghiên cứu đầy đủ, thành phần thường rất giàu protein, phospholipid, một số enzyme phosphatase kiềm và axit. Ngoài ra, bộ máy golgi cũng tạo ra các hạt chế tiết như melanosome (được tìm thấy trong sắc tố da và mắt). Protein được tạo ra trong lưới nội nội bào được chuyển đến bộ máy golgi để gắn thêm đuôi sunfat, cacbohydrat hoặc lipid vào các chuỗi axit amin cụ thể. Sau đó, chúng được kết hợp thành các hạt chế tiết hoặc lysosome.
- Lysosome: Lysosome có dạng túi, hình cầu hoặc hình trứng và được bao phủ bởi một lớp màng bọc (màng này bắt nguồn từ lưới nội bào hoặc bộ máy Golgi). Chức năng chính của bào quan này là tiêu hóa các chất, vì vậy chứa rất nhiều axit hydrolase và các enzym tiêu hóa. Bình thường, các enzym này không gây hại cho tế bào, nhưng khi các lysosome bị tổn thương và rò rỉ, các enzym tiêu hoá vào bào tương hoặc ra khỏi tế bào thì có thể gây hại cho cơ thể.
Màng tế bào
Màng tế bào là ranh giới phân tách tế bào với môi trường bên ngoài. Thành phần chính là protein, lipid và một số carbohydrate khác chẳng hạn như glycoprotein glycolipid. Các thành phần của màng tế bào được tổ chức thành hai lớp kép lipid với tính phân cực trong và ngoài màng.
Protein của màng tế bào đảm nhận nhiều chức năng khác nhau. Nhiệm vụ thứ nhất protein giúp vận chuyển các chất giữa tế bào và môi trường bên ngoài. Ngoài ra, protein là vị trí nhận thông tin từ các hormone và chất dẫn truyền hóa học ra nước ngoài và mang thông tin này về tế bào. Màng tế bào là một cấu trúc sống vì màng có thể tự biến đổi hóa học, tự sinh sản, thích nghi và điều hòa nên giúp các tổ chức phát triển và tồn tại.
Trong tế bào, màng tế bào chiếm 80% khối lượng đóng một vai trò vô cùng quan trọng là tạo ra các bào quan. Chức năng của màng tế bào bao gồm:
- Chuyển hóa năng lượng sinh học.
- Thông tin liên kết giữa các tế bào với nhau.
- Ngăn cách tế bào và bào quan khỏi môi trường bên ngoài nên giúp duy trì chức năng riêng biệt của từng bào quan.
Do đó, nếu màng tế bào bị tổn thương nặng có thể dẫn đến chết tế bào.
Màng tế bào là ranh giới phân tách tế bào với môi trường bên ngoài
Màng tế bào là ranh giới phân tách tế bào với môi trường bên ngoàiBài viết đã giới thiệu rõ tế bào là gì và cấu trúc, chức năng tế bào. Các tế bào trong cơ thể đều có chức năng riêng quan trọng đối với sức khoẻ của con người. Vì thế bảo vệ tế bào khỏe mạnh, hoạt động tốt chính là bảo vệ sức khỏe lâu dài của con người.
Cao Hiếu
Nguồn tham khảo: Tổng hợp
Có thể bạn quan tâm
Các bài viết liên quan
Lớp thượng bì: Cấu tạo, chức năng và bí quyết chăm sóc da khỏe đẹp
Lớp trung bì là gì? Cấu tạo, chức năng và cách chăm sóc
Cơ mông nhỡ là gì? Vai trò, chức năng và bài tập tăng cường hiệu quả
Hình ảnh tiêu xương ổ răng nhận biết mức độ tổn thương
Nhu mô thận: Cấu trúc, chức năng và các dấu hiệu cần biết
Tại sao lại mọc lông bụng ở nữ? Các phương pháp khắc phục tình trạng này
Tìm hiểu chi tiết midface là gì và vai trò trong thẩm mỹ?
Thể dục thủy sinh là gì? Những lợi ích cho sức khỏe bạn nên biết
Xương bàn tay gồm những gì? Cấu tạo và chức năng cần biết
Cháo sò lông: Món ăn bổ dưỡng và cách chế biến tại nhà
:format(webp)/Option_1_2_2d9677e5fd.png)
:format(webp)/Option_1_1_2a84e0cd00.png)
:format(webp)/ds_khanh_tuong_1_592bf2eb07.png)